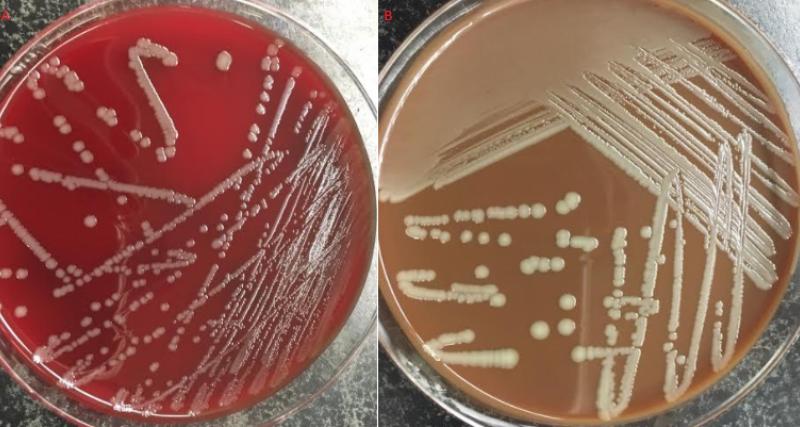
Septicemia Hemorrágica cultivo

Trámite orientado al diagnóstico de Septicemia Hemorrágica (Pasteurella multocida) mediante cultivo bacteriano y pruebas bioquímicas, Emisión de resultado de análisis, para la detección oportuna de enfermedades, problemas o patógenos, para la aplicación de medidas adecuadas para la prevención, control y atención de las mismas.
Los beneficiarios para poder acceder a este trámite son los siguientes:
Persona Jurídica - Privada: Legalmente constituidas.
Persona Natural - Ecuatoriana: Ciudadanos ecuatorianos mayores de 18 años.
Dirigido a: Persona Jurídica - Privada, Persona Natural - Ecuatoriana.
Informe de Diagnóstico de Septisemia Hemorrágica cultivo bioquímica
En línea:
1. Cotización
2. Orden de Trabajo
Presencial:
Una vez registrada la Orden de Trabajo y aprobado el pago en el sistema LIMS, proceder con:
Canales de atención: En línea (Sitio / Portal Web / Aplicación web), Presencial.
17,68 USD incluye IVA
Contacto: Amores Campaña Fabián Alejandro - Dirección de Diagnóstico Animal
Email: fabian.amores@agrocalidad.gob.ec
Teléfono: (+593) 23828860, ext 2065
Regula el desarrollo de actividades, servicios y la aplicación de medidas fito y zoosanitarias, con base a los principios técnico-científicos para la protección y mejoramiento de la sanidad animal y vegetal, así como para el incremento de la producción, la productividad y garantía de los derechos a la salud y a la vida; y el aseguramiento de la calidad de los productos agropecuarios.
| # | Año-Mes | Volumen de Quejas | Volumen de Atenciones |
|---|---|---|---|
| 1 | 2026-01 | 0 | 0 |
| 2 | 2026-02 | 0 | 0 |
| 3 | 2026-03 | 0 | 12 |
| 4 | 2026-04 | 0 | 32 |
| 5 | 2026-05 | 0 | 0 |
| 6 | 2025-01 | 0 | 0 |
| 7 | 2025-02 | 0 | 0 |
| 8 | 2025-03 | 0 | 0 |
| 9 | 2025-04 | 0 | 0 |
| 10 | 2025-05 | 0 | 0 |
| 11 | 2025-06 | 0 | 0 |
| 12 | 2025-07 | 0 | 0 |
| 13 | 2025-08 | 0 | 0 |
| 14 | 2025-09 | 0 | 0 |
| 15 | 2025-10 | 0 | 0 |
| 16 | 2025-11 | 0 | 0 |
| 17 | 2025-12 | 0 | 0 |
| 18 | 2024-01 | 0 | 0 |
| 19 | 2024-02 | 0 | 0 |
| 20 | 2024-03 | 0 | 0 |
| 21 | 2024-04 | 0 | 0 |
| 22 | 2024-05 | 0 | 1 |
| 23 | 2024-06 | 0 | 0 |
| 24 | 2024-07 | 0 | 0 |
| 25 | 2024-08 | 0 | 0 |
| 26 | 2024-09 | 0 | 4 |
| 27 | 2024-10 | 0 | 0 |
| 28 | 2024-11 | 0 | 0 |
| 29 | 2024-12 | 0 | 0 |
| 30 | 2023-01 | 0 | 0 |
| 31 | 2023-02 | 0 | 0 |
| 32 | 2023-03 | 0 | 0 |
| 33 | 2023-04 | 0 | 0 |
| 34 | 2023-05 | 0 | 0 |
| 35 | 2023-06 | 0 | 0 |
| 36 | 2023-07 | 0 | 0 |
| 37 | 2023-08 | 0 | 0 |
| 38 | 2023-09 | 0 | 0 |
| 39 | 2023-10 | 0 | 0 |
| 40 | 2023-11 | 0 | 0 |
| 41 | 2023-12 | 0 | 0 |
| 42 | 2022-01 | 0 | 0 |
| 43 | 2022-02 | 0 | 0 |
| 44 | 2022-03 | 0 | 0 |
| 45 | 2022-04 | 0 | 0 |
| 46 | 2022-05 | 0 | 0 |
| 47 | 2022-06 | 0 | 0 |
| 48 | 2022-07 | 0 | 0 |
| 49 | 2022-08 | 0 | 0 |
| 50 | 2022-09 | 0 | 0 |
| 51 | 2022-10 | 0 | 0 |
| 52 | 2022-11 | 0 | 0 |
| 53 | 2022-12 | 0 | 0 |
| 54 | 2021-01 | 0 | 0 |
| 55 | 2021-02 | 0 | 0 |
| 56 | 2021-03 | 0 | 0 |
| 57 | 2021-04 | 0 | 0 |
| 58 | 2021-05 | 0 | 0 |
| 59 | 2021-06 | 0 | 0 |
| 60 | 2021-07 | 0 | 0 |
| 61 | 2021-08 | 0 | 0 |
| 62 | 2021-09 | 0 | 0 |
| 63 | 2021-10 | 0 | 0 |
| 64 | 2021-11 | 0 | 0 |
| 65 | 2021-12 | 0 | 0 |
| 66 | 2020-01 | 0 | 0 |
| 67 | 2020-02 | 0 | 0 |
| 68 | 2020-03 | 0 | 0 |
| 69 | 2020-04 | 0 | 0 |
| 70 | 2020-05 | 0 | 0 |
| 71 | 2020-06 | 0 | 0 |
| 72 | 2020-07 | 0 | 1 |
| 73 | 2020-08 | 0 | 0 |
| 74 | 2020-09 | 0 | 0 |
| 75 | 2020-10 | 0 | 0 |
| 76 | 2020-11 | 0 | 0 |
| 77 | 2020-12 | 0 | 0 |
| 78 | 2019-01 | 0 | 0 |
| 79 | 2019-02 | 0 | 0 |
| 80 | 2019-03 | 0 | 0 |
| 81 | 2019-04 | 0 | 0 |
| 82 | 2019-05 | 0 | 0 |
| 83 | 2019-06 | 0 | 0 |
| 84 | 2019-07 | 0 | 0 |
| 85 | 2019-08 | 0 | 0 |
| 86 | 2019-09 | 0 | 0 |
| 87 | 2019-10 | 0 | 0 |
| 88 | 2019-11 | 0 | 0 |
| 89 | 2019-12 | 0 | 11 |
| 90 | 2018-08 | 0 | 6 |
| 91 | 2017-12 | 0 | 5 |
Fecha de última actualización: 2025/08/05